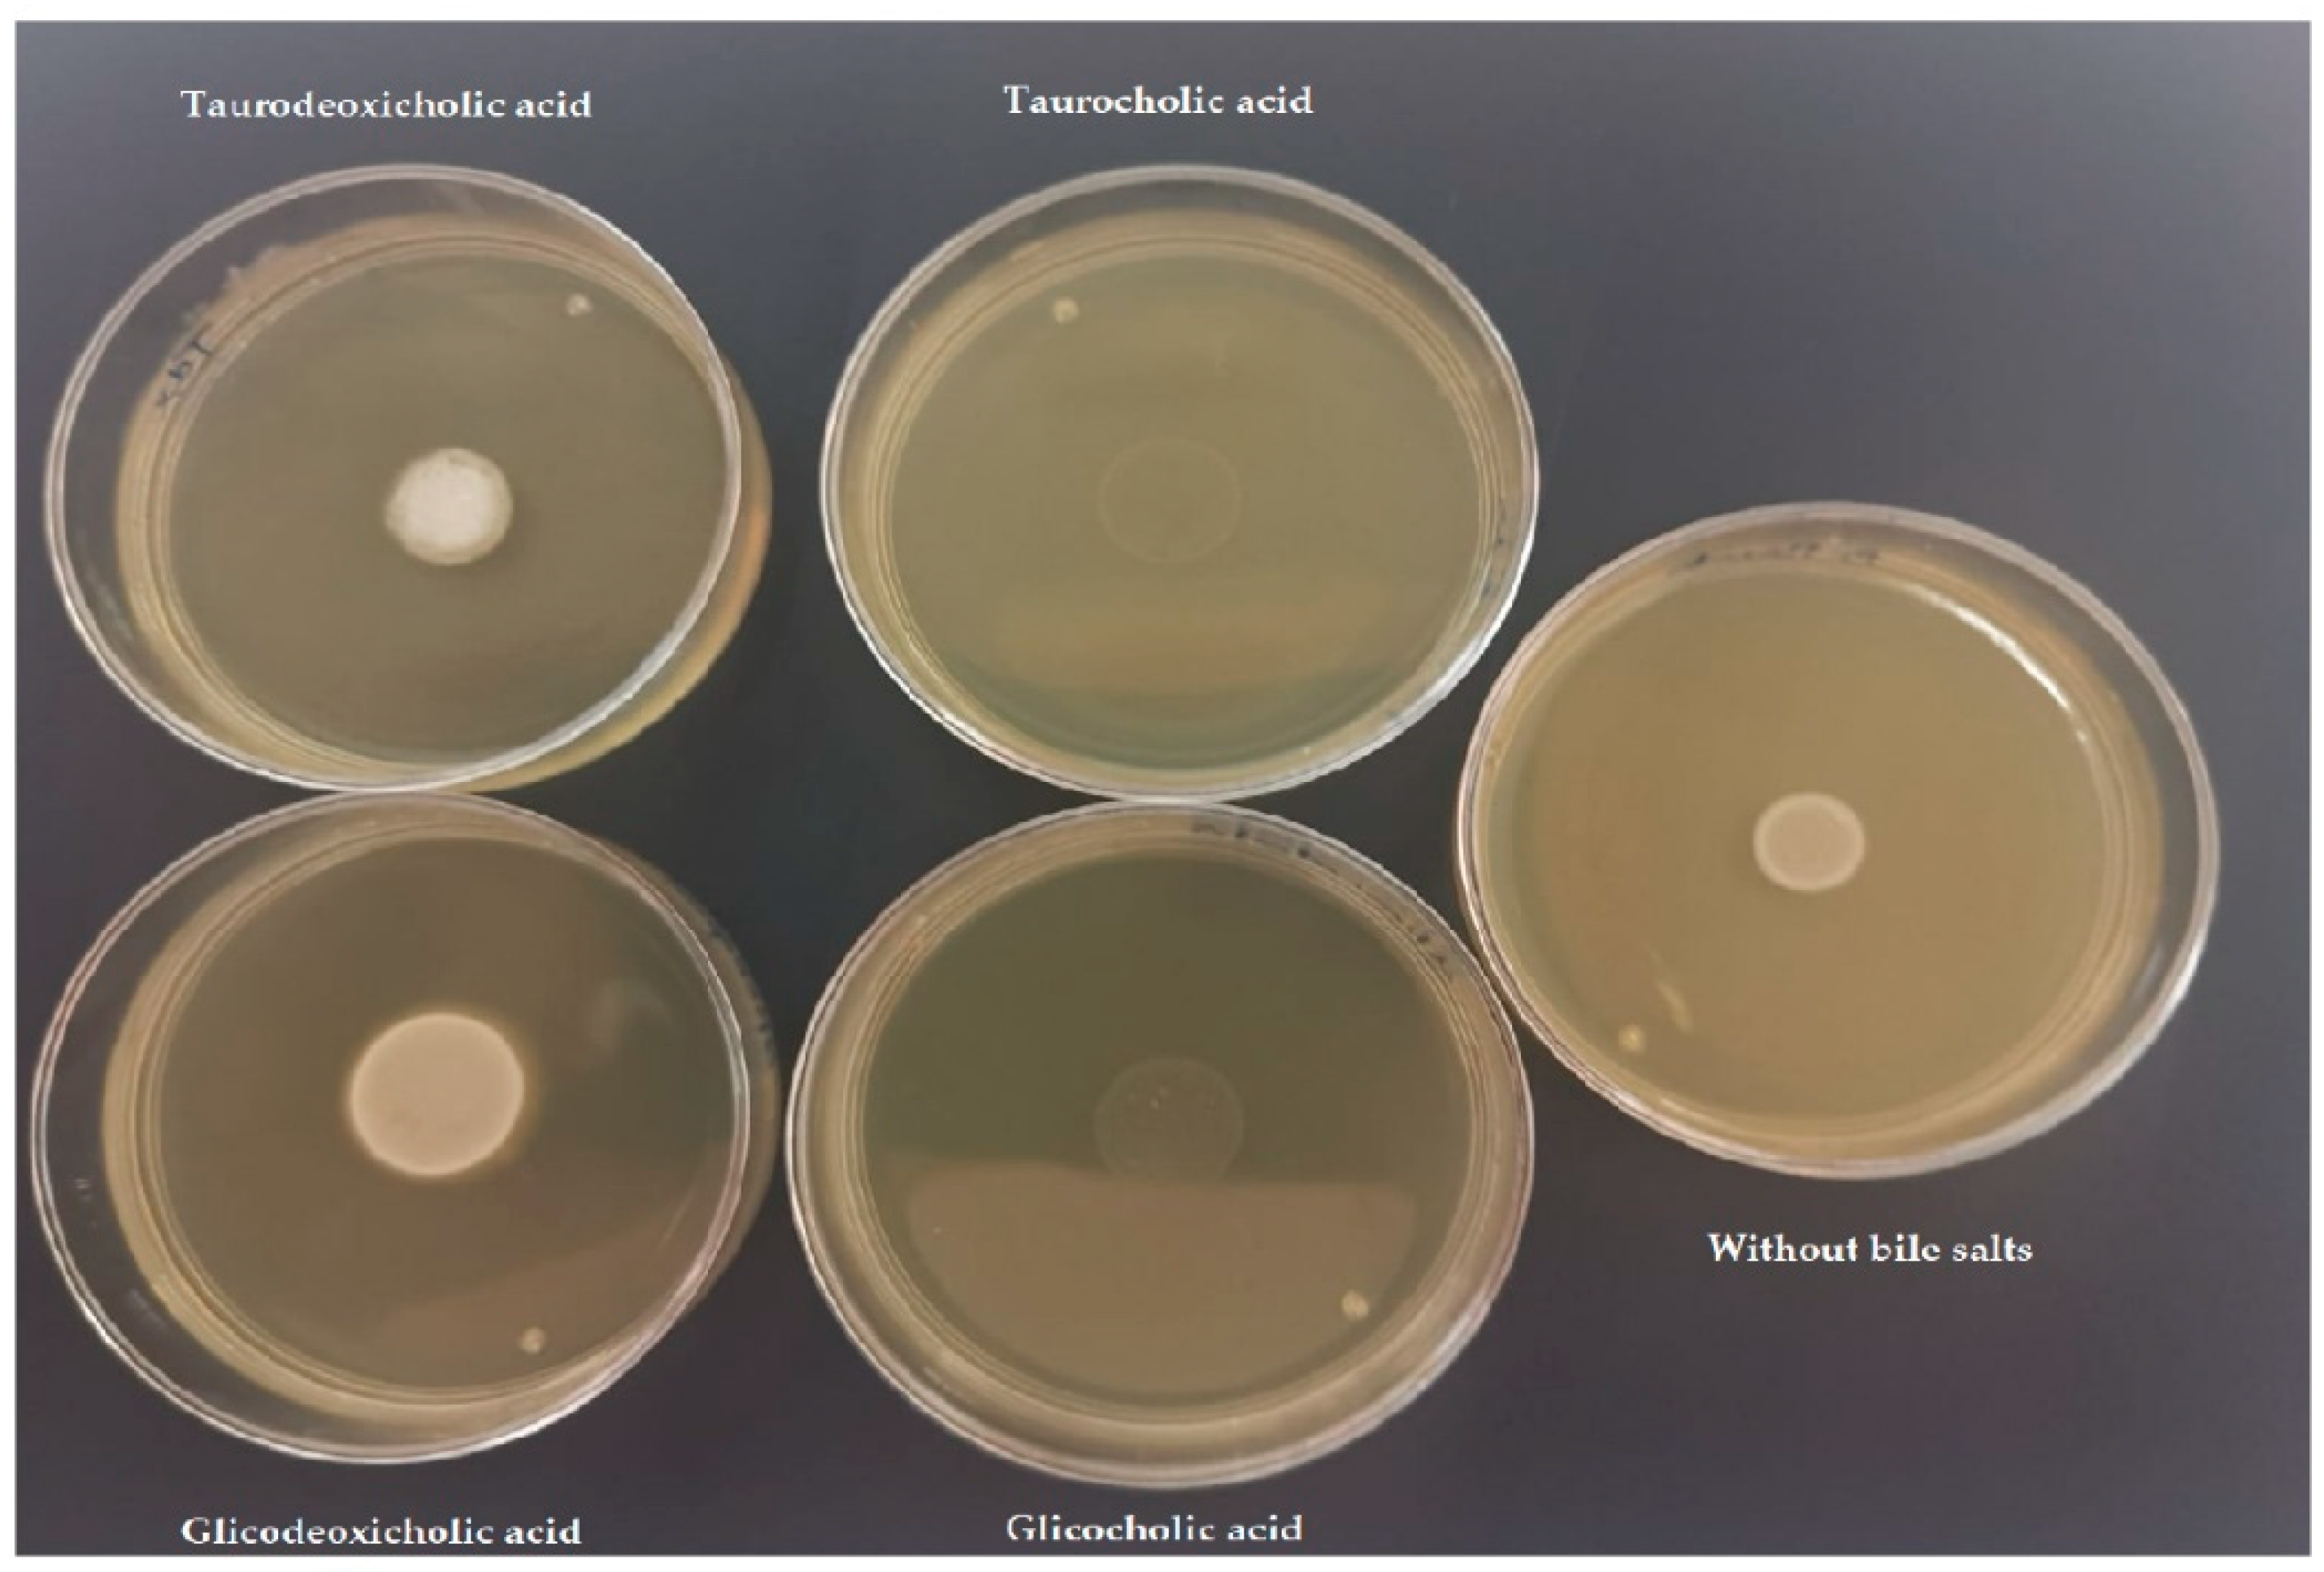

Genomic and Biochemical Characterization of Bifidobacterium pseudocatenulatum JCLA3 Isolated from Human Intestine
Abstract
1. Introduction
2. Materials and Methods
2.1. Isolation
2.2. DNA Extraction and Genotypic Identification
2.3. Multilocus Sequence Analysis (MLSA)
2.4. Genome Sequencing and Annotation
2.5. Effect of Carbon Source on Growth of B. pseudocatenulatum JCLA3
2.6. Antibiotic Profile
2.7. Hemolysis Test
2.8. Antimicrobial Activity
2.9. Bile Salt Tolerance Assay
2.10. Tolerance to the Gastrointestinal Tract (GIT)
2.11. DPPH Radical Scavenging Activity Assay
2.12. Adhesion Assay
2.13. Statistical Analysis
3. Results
3.1. Genotypic Identification
3.2. Genome Analysis
3.3. Biochemical Characterization of B. pseudocatenulatum JCLA3
3.3.1. Effect of Carbon Source on Growth
3.3.2. Antibiotic Profile
3.3.3. Hemolysis Test
3.3.4. Antimicrobial Activity
3.3.5. Bile Salt Tolerance
3.3.6. Tolerance to the Gastrointestinal Tract
3.3.7. DPPH Radical Scavenging Activity Assay
3.3.8. Adhesion Assay
4. Discussion
5. Conclusions
Supplementary Materials
Author Contributions
Funding
Data Availability Statement
Acknowledgments
Conflicts of Interest
References
- Duranti, S.; Ruiz, L.; Lugli, G.A.; Tames, H.; Milani, C.; Mancabelli, L.; Mancino, W.; Longhi, G.; Carnevali, L.; Sgoifo, A.; et al. Bifidobacterium adolescentis as a key member of the human gut microbiota in the production of GABA. Sci. Rep. 2020, 10, 14112. [Google Scholar] [CrossRef]
- Lawson, M.A.E.; O’Neill, I.J.; Kujawska, M.; Gowrinadh Javvadi, S.; Wijeyesekera, A.; Flegg, Z.; Chalklen, L.; Hall, L.J. Breast milk-derived human milk oligosaccharides promote Bifidobacterium interactions within a single ecosystem. ISME J. 2020, 14, 635–648. [Google Scholar] [CrossRef]
- Salazar, N.; Neyrinck, A.M.; Bindels, L.B.; Druart, C.; Ruas-Madiedo, P.; Cani, P.D.; de Los Reyes-Gavilán, C.G.; Delzenne, N.M. Functional Effects of EPS-Producing Bifidobacterium Administration on Energy Metabolic Alterations of Diet-Induced Obese Mice. Front. Microbiol. 2019, 10, 1809. [Google Scholar] [CrossRef]
- Moya-Pérez, A.; Neef, A.; Sanz, Y. Bifidobacterium pseudocatenulatum CECT 7765 Reduces Obesity-Associated Inflammation by Restoring the Lymphocyte-Macrophage Balance and Gut Microbiota Structure in High-Fat Diet-Fed Mice. PLoS ONE 2015, 10, e0126976. [Google Scholar] [CrossRef] [PubMed]
- Leahy, S.C.; Higgins, D.G.; Fitzgerald, G.F.; van Sinderen, D. Getting better with bifidobacteria. J. Appl. Microbiol. 2005, 98, 1303–1315. [Google Scholar] [CrossRef] [PubMed]
- Usta-Gorgun, B.; Yilmaz-Ersan, L. Short-chain fatty acids production by Bifidobacterium species in the presence of salep. Electron. J. Biotechnol. 2020, 47, 29–35. [Google Scholar] [CrossRef]
- Cronin, M.; Ventura, M.; Fitzgerald, G.F.; van Sinderen, D. Progress in genomics, metabolism and biotechnology of bifidobacteria. Int. J. Food Microbiol. 2011, 149, 4–18. [Google Scholar] [CrossRef] [PubMed]
- EFSA Panel on Additives and Products or Substances used in Animal Feed (FEEDAP); Rychen, G.; Aquilina, G.; Azimonti, G.; Bampidis, V.; Bastos, M.d.L.; Bories, G.; Chesson, A.; Cocconcelli, P.S.; Flachowsky, G.; et al. Guidance on the characterisation of microorganisms used as feed additives or as production organisms. EFSA J. 2018, 16, e05206. [Google Scholar] [CrossRef]
- Alegría, Á.; Delgado, S.; Guadamuro, L.; Flórez, A.B.; Felis, G.E.; Torriani, S.; Mayo, B. The genome of Bifidobacterium pseudocatenulatum IPLA 36007, a human intestinal strain with isoflavone-activation activity. Gut Pathog. 2014, 6, 31. [Google Scholar] [CrossRef] [PubMed]
- Wang, J.; Qie, J.; Zhu, D.; Zhang, X.; Zhang, Q.; Xu, Y.; Wang, Y.; Mi, K.; Pei, Y.; Liu, Y.; et al. The landscape in the gut microbiome of long-lived families reveals new insights on longevity and aging—relevant neural and immune function. Gut Microbes 2022, 14, 2107288. [Google Scholar] [CrossRef] [PubMed]
- Olvera, R.N.; Gutiérrez, N.A.; Azaola, E.A.; Mayorga, R.L. Characterization of a Bifidobacterium sp. strain isolated from human faeces and its expression of the ack and ldh genes. Afr. J. Microbiol. Res. 2013, 7, 5713–5718. [Google Scholar] [CrossRef]
- Kok, R.G.; de Waal, A.; Schut, F.; Welling, G.W.; Weenk, G.; Hellingwerf, K.J. Specific detection and analysis of a probiotic Bifidobacterium strain in infant feces. Appl. Environ. Microbiol. 1996, 62, 3668–3672. [Google Scholar] [CrossRef] [PubMed]
- Tamura, K.; Peterson, D.; Peterson, N.; Stecher, G.; Nei, M.; Kumar, S. MEGA5: Molecular evolutionary genetics analysis using maximum likelihood, evolutionary distance, and maximum parsimony methods. Mol. Biol. Evol. 2011, 28, 2731–2739. [Google Scholar] [CrossRef] [PubMed]
- Ventura, M.; Canchaya, C.; Casale, A.D.; Franco, D.; Erasmo, N.; Fitzgerald, G.F.; Sinderen, D.v. Analysis of bifidobacterial evolution using a multilocus approach. Int. J. Syst. Evol. Microbiol. 2006, 56, 2783–2792. [Google Scholar] [CrossRef] [PubMed]
- Thompson, J.D.; Higgins, D.G.; Gibson, T.J. CLUSTAL W: Improving the sensitivity of progressive multiple sequence alignment through sequence weighting, position-specific gap penalties and weight matrix choice. Nucleic Acids Res. 1994, 22, 4673–4680. [Google Scholar] [CrossRef] [PubMed]
- Kimura, M. A simple method for estimating evolutionary rates of base substitutions through comparative studies of nucleotide sequences. J. Mol. Evol. 1980, 16, 111–120. [Google Scholar] [CrossRef] [PubMed]
- Kumar, S.; Stecher, G.; Tamura, K. MEGA7: Molecular Evolutionary Genetics Analysis Version 7.0 for Bigger Datasets. Mol. Biol. Evol. 2016, 33, 1870–1874. [Google Scholar] [CrossRef] [PubMed]
- Comeau André, M.; Douglas Gavin, M.; Langille Morgan, G.I. Microbiome Helper: A Custom and Streamlined Workflow for Microbiome Research. mSystems 2017, 2, e00127-16. [Google Scholar] [CrossRef]
- Seemann, T. Prokka: Rapid prokaryotic genome annotation. Bioinformatics 2014, 30, 2068–2069. [Google Scholar] [CrossRef] [PubMed]
- Hyatt, D.; Chen, G.L.; Locascio, P.F.; Land, M.L.; Larimer, F.W.; Hauser, L.J. Prodigal: Prokaryotic gene recognition and translation initiation site identification. BMC Bioinform. 2010, 11, 119. [Google Scholar] [CrossRef] [PubMed]
- Karin, L.; Peter, H.; Andreas, R.E.; Hans-Henrik, S.; Torbjørn, R.; Ussery, D.W. RNAmmer:consistent and rapid annotation of ribosomal RNA genes. Nucleic Acids Res. 2007, 35, 3100–3108. [Google Scholar] [CrossRef]
- Laslett, D.; Canback, B. ARAGORN, a program to detect tRNA genes and tmRNA genes in nucleotide sequences. Nucleic Acids Res. 2004, 32, 11–16. [Google Scholar] [CrossRef] [PubMed]
- Grissa, I.; Vergnaud, G.; Pourcel, C. CRISPRFinder: A web tool to identify clustered regularly interspaced short palindromic repeats. Nucleic Acids Res. 2007, 35, W52–W57. [Google Scholar] [CrossRef] [PubMed]
- Kalvari, I.; PNawrocki, E.; Argasinska, J.; Quinones-Olvera, N.; DFinn, R.; Bateman, A.; IPetrov, A. Non-coding RNA analysis using the Rfam database. Curr. Protoc. Bioinform. 2018, 62, 351. [Google Scholar] [CrossRef]
- Eddy, S.R. Accelerated Profile HMM Searches. PLoS Comput. Biol. 2011, 7, e1002195. [Google Scholar] [CrossRef] [PubMed]
- Huerta-Cepas, J.; Szklarczyk, D.; Heller, D.; Hernández-Plaza, A.; Forslund, S.K.; Cook, H.; Mende, D.R.; Letunic, I.; Rattei, T.; Jensen, L.J.; et al. eggNOG 5.0: A hierarchical, functionally and phylogenetically annotated orthology resource based on 5090 organisms and 2502 viruses. Nucleic Acids Res. 2019, 47, D309–D314. [Google Scholar] [CrossRef] [PubMed]
- Taboada, B.; Estrada, K.; Ciria, R.; Merino, E. Operon-mapper: A web server for precise operon identification in bacterial and archaeal genomes. Bioinformatics 2018, 34, 4118–4120. [Google Scholar] [CrossRef] [PubMed]
- González-Vázquez, R.; Azaola-Espinosa, A.; Mayorga-Reyes, L.; Reyes-Nava, L.A.; Shah, N.P.; Rivera-Espinoza, Y. Isolation, Identification and Partial Characterization of a Lactobacillus casei Strain with Bile Salt Hydrolase Activity from Pulque. Probiotics Antimicrob. Proteins 2015, 7, 242–248. [Google Scholar] [CrossRef] [PubMed]
- Presti, I.; D’Orazio, G.; Labra, M.; La Ferla, B.; Mezzasalma, V.; Bizzaro, G.; Giardina, S.; Michelotti, A.; Tursi, F.; Vassallo, M.; et al. Evaluation of the probiotic properties of new Lactobacillus and Bifidobacterium strains and their in vitro effect. Appl. Microbiol. Biotechnol. 2015, 99, 5613–5626. [Google Scholar] [CrossRef] [PubMed]
- Zuo, F.; Yu, R.; Feng, X.; Chen, L.; Zeng, Z.; Khaskheli, G.B.; Ma, H.; Chen, S. Characterization and in vitro properties of potential probiotic Bifidobacterium strains isolated from breast-fed infant feces. Ann. Microbiol. 2016, 66, 1027–1037. [Google Scholar] [CrossRef]
- Olivares-Romero, R.; Faustino, A.; Miranda-Calderon, J.E.; González-Vázquez, R.; Azaola-Espinosa, A. Microencapsulation of Lactobacillus acidophilus LA-5 increases relative survival under simulated gastrointestinal tract stress. Rev. Mex. Ing. Químic 2018, 17, 641–650. [Google Scholar] [CrossRef]
- Su, J.; Wang, T.; Li, Y.-Y.; Li, J.; Zhang, Y.; Wang, Y.; Wang, H.; Li, H. Antioxidant properties of wine lactic acid bacteria: Oenococcus oeni. Appl. Microbiol. Biotechnol. 2015, 99, 5189–5202. [Google Scholar] [CrossRef] [PubMed]
- Muñoz-Provencio, D.; Pérez-Martínez, G.; Monedero, V. Characterization of a fibronectin-binding protein from Lactobacillus casei BL23. J. Appl. Microbiol. 2010, 108, 1050–1059. [Google Scholar] [CrossRef]
- Duboux, S.; Muller, J.A.; De Franceschi, F.; Mercenier, A.; Kleerebezem, M. Using fluorescent promoter-reporters to study sugar utilization control in Bifidobacterium longum NCC 2705. Sci. Rep. 2022, 12, 10477. [Google Scholar] [CrossRef]
- Schell, M.A.; Karmirantzou, M.; Snel, B.; Vilanova, D.; Berger, B.; Pessi, G.; Zwahlen, M.C.; Desiere, F.; Bork, P.; Delley, M.; et al. The genome sequence of Bifidobacterium longum reflects its adaptation to the human gastrointestinal tract. Proc. Natl. Acad. Sci. USA 2002, 99, 14422–14427. [Google Scholar] [CrossRef] [PubMed]
- Pokusaeva, K.; Fitzgerald, G.F.; van Sinderen, D. Carbohydrate metabolism in Bifidobacteria. Genes Nutr. 2011, 6, 285–306. [Google Scholar] [CrossRef] [PubMed]
- De Vuyst, L.; Leroy, F. Cross-feeding between bifidobacteria and butyrate-producing colon bacteria explains bifdobacterial competitiveness, butyrate production, and gas production. Int. J. Food Microbiol. 2011, 149, 73–80. [Google Scholar] [CrossRef]
- Moens, F.; Verce, M.; De Vuyst, L. Lactate- and acetate-based cross-feeding interactions between selected strains of lactobacilli, bifidobacteria and colon bacteria in the presence of inulin-type fructans. Int. J. Food Microbiol. 2017, 241, 225–236. [Google Scholar] [CrossRef]
- James, K.; van Sinderen, D. Site-Directed Mutagenesis of Bifidobacterium Strains. Methods Mol. Biol. 2021, 2278, 45–60. [Google Scholar] [CrossRef]
- Torres-Maravilla, E.; Reyes-Pavón, D.; Benítez-Cabello, A.; González-Vázquez, R.; Ramírez-Chamorro, L.M.; Langella, P.; Bermúdez-Humarán, L.G. Strategies for the Identification and Assessment of Bacterial Strains with Specific Probiotic Traits. Microorganisms 2022, 10, 1389. [Google Scholar] [CrossRef]
- Liong, M.T.; Shah, N. Bile salt deconjugation and BSH activity of five bifidobacterial strains and their cholesterol co-precipitating properties. Food Res. Int. 2005, 38, 135–142. [Google Scholar] [CrossRef]
- Öner, Ö.; Aslim, B.; Aydaş, S.B. Mechanisms of cholesterol-lowering effects of lactobacilli and bifidobacteria strains as potential probiotics with their bsh gene analysis. J. Mol. Microbiol. Biotechnol. 2014, 24, 12–18. [Google Scholar] [CrossRef] [PubMed]
- Kim, G.B.; Yi, S.H.; Lee, B.H. Purification and Characterization of Three Different Types of Bile Salt Hydrolases from Bifidobacterium Strains. J. Dairy Sci. 2004, 87, 258–266. [Google Scholar] [CrossRef]
- Moubareck, C.; Gavini, F.; Vaugien, L.; Butel, M.J.; Doucet-Populaire, F. Antimicrobial susceptibility of bifidobacteria. J. Antimicrob. Chemother. 2005, 55, 38–44. [Google Scholar] [CrossRef]
- Guadamuro, L.; Flórez, A.B.; Alegría, Á.; Vázquez, L.; Mayo, B. Characterization of four β-glucosidases acting on isoflavone-glycosides from Bifidobacterium pseudocatenulatum IPLA 36007. Food Res. Int. 2017, 100, 522–528. [Google Scholar] [CrossRef]
- Di Gioia, D.; Strahsburger, E.; Lopez de Lacey, A.M.; Bregola, V.; Marotti, I.; Aloisio, I.; Biavati, B.; Dinelli, G. Flavonoid bioconversion in Bifidobacterium pseudocatenulatum B7003: A potential probiotic strain for functional food development. J. Funct. Foods 2014, 7, 671–679. [Google Scholar] [CrossRef]
- Delgado, S.; Flórez, A.B.; Mayo, B. Antibiotic susceptibility of Lactobacillus and Bifidobacterium species from the human gastrointestinal tract. Curr. Microbiol. 2005, 50, 202–207. [Google Scholar] [CrossRef]
- Cizeikiene, D.; Jagelaviciute, J. Investigation of Antibacterial Activity and Probiotic Properties of Strains Belonging to Lactobacillus and Bifidobacterium Genera for Their Potential Application in Functional Food and Feed Products. Probiotics Antimicrob. Proteins 2021, 13, 1387–1403. [Google Scholar] [CrossRef]
- Martinez, F.A.; Balciunas, E.M.; Converti, A.; Cotter, P.D.; de Souza Oliveira, R.P. Bacteriocin production by Bifidobacterium spp. A review. Biotechnol. Adv. 2013, 31, 482–488. [Google Scholar] [CrossRef]
- Lahtinen, S.J.; Jalonen, L.; Ouwehand, A.C.; Salminen, S.J. Specific Bifidobacterium strains isolated from elderly subjects inhibit growth of Staphylococcus aureus. Int. J. Food Microbiol. 2007, 117, 125–128. [Google Scholar] [CrossRef]
- Makras, L.; De Vuyst, L. The in vitro inhibition of Gram-negative pathogenic bacteria by bifidobacteria is caused by the production of organic acids. Int. Dairy J. 2006, 16, 1049–1057. [Google Scholar] [CrossRef]
- Ziarno, M.; Zaręba, D. Effects of milk components and food additives on survival of three bifidobacteria strains in fermented milk under simulated gastrointestinal tract conditions. Microb. Ecol. Health Dis. 2015, 26, 27812. [Google Scholar] [CrossRef] [PubMed]
- Kelly, S.M.; Lanigan, N.; O’Neill, I.J.; Bottacini, F.; Lugli, G.A.; Viappiani, A.; Turroni, F.; Ventura, M.; van Sinderen, D. Bifidobacterial biofilm formation is a multifactorial adaptive phenomenon in response to bile exposure. Sci. Rep. 2020, 10, 11598. [Google Scholar] [CrossRef] [PubMed]
- Pyclik, M.; Srutkova, D.; Schwarzer, M.; Górska, S. Bifidobacteria cell wall-derived exo-polysaccharides, lipoteichoic acids, peptidoglycans, polar lipids and proteins—their chemical structure and biological attributes. Int. J. Biol. Macromol. 2020, 147, 333–349. [Google Scholar] [CrossRef] [PubMed]
- Pereira, C.S.; Thompson, J.A.; Xavier, K.B. AI-2-mediated signalling in bacteria. FEMS Microbiol. Rev. 2013, 37, 156–181. [Google Scholar] [CrossRef]
- Jungersen, M.; Wind, A.; Johansen, E.; Christensen, J.E.; Stuer-Lauridsen, B.; Eskesen, D. The Science behind the Probiotic Strain Bifidobacterium animalis subsp. lactis BB-12(®). Microorganisms 2014, 2, 92–110. [Google Scholar] [CrossRef]
- Zhang, J.; Wang, S.; Zeng, Z.; Qin, Y.; Li, P. The complete genome sequence of Bifidobacterium animalis subsp. lactis 01 and its integral components of antioxidant defense system. 3 Biotech 2019, 9, 352. [Google Scholar] [CrossRef]
- Shen, Q.; Shang, N.; Li, P. In vitro and in vivo antioxidant activity of Bifidobacterium animalis 01 isolated from centenarians. Curr. Microbiol. 2011, 62, 1097–1103. [Google Scholar] [CrossRef]
- Kim, J.Y.; Choi, S.I.; Heo, T.R. Screening of antioxidative activity ofBifidobacterium species isolated from Korean infant feces and their identification. Biotechnol. Bioprocess Eng. 2003, 8, 199–204. [Google Scholar] [CrossRef]
- Lin, M.Y.; Yen, C.L. Inhibition of lipid peroxidation by Lactobacillus acidophilus and Bifidobacterium longum. J. Agric. Food Chem. 1999, 47, 3661–3664. [Google Scholar] [CrossRef]
- Inturri, R.; Molinaro, A.; Di Lorenzo, F.; Blandino, G.; Tomasello, B.; Hidalgo-Cantabrana, C.; De Castro, C.; Ruas-Madiedo, P. Chemical and biological properties of the novel exopolysaccharide produced by a probiotic strain of Bifidobacterium longum. Carbohydr. Polym. 2017, 174, 1172–1180. [Google Scholar] [CrossRef] [PubMed]
- Westermann, C.; Gleinser, M.; Corr, S.C.; Riedel, C.U. A Critical Evaluation of Bifidobacterial Adhesion to the Host Tissue. Front. Microbiol. 2016, 7, 1220. [Google Scholar] [CrossRef] [PubMed]

| Strains | ||
|---|---|---|
| B. pseudocatenulatum JCLA3 | B. animalis subsp. lactis Bb-12 | |
| (a) Antibiotic profile * Vancomycin | S | S |
| Ampicillin | R | R |
| Trimethoprim sulfamethoxazole | S | S |
| Gentamicin | S | S |
| Dicloxacillin | S | R |
| Cephalothin | R | R |
| Clindamycin | S | S |
| Erythromycin | S | S |
| Penicillin | S | S |
| Tetracycline | S | R |
| Cefotaxime | S | S |
| Ciprofloxacin | S | R |
| (b) Hemolysis | − | − |
| (c) Antimicrobial activity | ||
| E. coli ATCC 25922 | + | ++ |
| Escherichia coli O157: H7 | − | ++ |
| Salmonella typhi ATCC14028 | − | ++ |
| Staphylococcus aureus ATCC 6538 | + | + |
| (d) Bile salt tolerance assay | ||
| Glycocholic acid 0.1–0.5% | + | + |
| Taurocholic acid 0.1–0.5% | + | + |
| Glycodeoxycholic acid 0.1–0.5% | + | + |
| Taurodeoxycholic acid 0.1–0.5% | + | + |
| (e) Tolerance to GIT | ||
| Simulated saliva | 100% | 100% |
| Simulated gastric fluid | 0% | 2.26% |
| Simulated intestinal fluid | 0% | 0% |
Publisher’s Note: MDPI stays neutral with regard to jurisdictional claims in published maps and institutional affiliations. |
© 2022 by the authors. Licensee MDPI, Basel, Switzerland. This article is an open access article distributed under the terms and conditions of the Creative Commons Attribution (CC BY) license (https://creativecommons.org/licenses/by/4.0/).
Share and Cite
González-Vázquez, R.; Zúñiga-León, E.; Torres-Maravilla, E.; Leyte-Lugo, M.; Mendoza-Pérez, F.; Hernández-Delgado, N.C.; Pérez-Pastén-Borja, R.; Azaola-Espinosa, A.; Mayorga-Reyes, L. Genomic and Biochemical Characterization of Bifidobacterium pseudocatenulatum JCLA3 Isolated from Human Intestine. Microorganisms 2022, 10, 2100. https://doi.org/10.3390/microorganisms10112100
González-Vázquez R, Zúñiga-León E, Torres-Maravilla E, Leyte-Lugo M, Mendoza-Pérez F, Hernández-Delgado NC, Pérez-Pastén-Borja R, Azaola-Espinosa A, Mayorga-Reyes L. Genomic and Biochemical Characterization of Bifidobacterium pseudocatenulatum JCLA3 Isolated from Human Intestine. Microorganisms. 2022; 10(11):2100. https://doi.org/10.3390/microorganisms10112100
Chicago/Turabian StyleGonzález-Vázquez, Raquel, Eduardo Zúñiga-León, Edgar Torres-Maravilla, Martha Leyte-Lugo, Felipe Mendoza-Pérez, Natalia C. Hernández-Delgado, Ricardo Pérez-Pastén-Borja, Alejandro Azaola-Espinosa, and Lino Mayorga-Reyes. 2022. "Genomic and Biochemical Characterization of Bifidobacterium pseudocatenulatum JCLA3 Isolated from Human Intestine" Microorganisms 10, no. 11: 2100. https://doi.org/10.3390/microorganisms10112100
APA StyleGonzález-Vázquez, R., Zúñiga-León, E., Torres-Maravilla, E., Leyte-Lugo, M., Mendoza-Pérez, F., Hernández-Delgado, N. C., Pérez-Pastén-Borja, R., Azaola-Espinosa, A., & Mayorga-Reyes, L. (2022). Genomic and Biochemical Characterization of Bifidobacterium pseudocatenulatum JCLA3 Isolated from Human Intestine. Microorganisms, 10(11), 2100. https://doi.org/10.3390/microorganisms10112100

